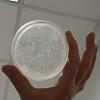
Na Institutu za genetičko inženjerstvo i biotehnologiju UNSA uspješno izveden eksperiment genomskog editovanja nepatogenog soja E. coli CRISPR-Cas9 tehnologijom

Na Institutu za genetičko inženjerstvo i biotehnologiju UNSA uspješno izveden eksperiment genomskog editovanja nepatogenog soja E. coli CRISPR-Cas9 tehnologijom

U aprilu ove godine je, prvi put u BiH, na Institutu za genetičko inženjerstvo i biotehnologiju Univerziteta u Sarajevu, uspješno izveden eksperiment genomskog editovanja nepatogenog soja E. coli CRISPR-Cas9 tehnologijom.
Tim predvođen prof. dr. Lejlom Pojskić je genetičkom bakterijskom transformacijom, koristeći CRISPR-Cas9 tehniku, modificirao DH5-α soj E.coli. Novotransformirane bakterijske ćelije nose izmijenjen i stabilno inkorporiran marker gen za streptomicinsku rezistentnost.
Premijernom primjenom CRISPR-Cas9 tehnike genetičkog inženjerstva na INGEB-u su otvorene nove mogućnosti za razvoj istraživačkih i obrazovnih kapaciteta u oblasti molekularne i aplikativne genetike kao važne komponente razvoja Instituta za genetičko inženjerstvo i biotehnologiju i Univerziteta u Sarajevu. Projekat Open Biotech Platform se realizira zahvaljujući podršci Ministarstva za nauku, visoko obrazovanje i mlade KS.